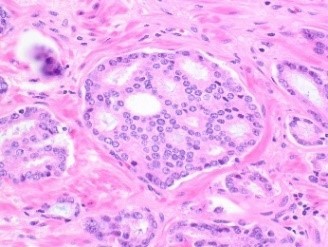

Overview
The Division of Anatomic Pathology at the University of Alabama at Birmingham, offers a one-year fellowship experience in Genitourinary (GU) pathology. The University of Alabama at Birmingham (UAB) Surgical Pathology laboratory performs approximately 50,000 surgical cases yearly, of which ~2500 are GU cases comprising benign and malignant conditions of prostate, bladder, kidney, testis, penis and adrenal gland, from different specimen types, including needle biopsies, resections, and consult cases. Fellows actively participate in previewing and signing out all types of GU cases. Sign-out privileges are also anticipated for fellows with appropriate qualifications for both routine and frozen section services. Opportunities for elective rotation in subspecialty areas of Surgical Pathology are available, making the program flexible and individually tailored. There are multiple interdisciplinary conferences at UAB (including GU and multidisciplinary tumor board, among others) in which fellows may actively participate. Fellows are encouraged to participate in ongoing basic, translational or applied research projects in collaboration with the more than two dozen faculty members in the Division, leading to publications and presentations at national meetings. Rotations are entirely at The University of Alabama Hospital. The program is optimized with structured didactic lectures and slide sessions relevant to daily practice. A combined GYN/GU one-year fellowship option is also available.
This fellowship program is directed by Cristina Magi-Galluzzi, MD, PhD, Professor of Pathology.
Meet Our Genitourinary Pathology Faculty
Cristina Magi-Galluzzi, M.D., Ph.D.
Robert and Ruth Anderson Endowed Chair
Section Head, GU Pathology
Director, Genitourinary Pathology Fellowship Program
Valeria Dal Zotto, M.D.
Assistant Professor, Women's Health
Requirements
MD degree and completion of pathology core requirements (3 years of AP or 4 years of combined AP/CP training.) Previous Surgical Pathology or Cytopathology training is preferred.
Stipends
Stipends are commensurate with the level of postgraduate training in Pathology. Also provided is a professional development fund and a generous relocation allowance.
Applications
Submit application along with curriculum vitae and three letters of recommendation, including one from current program director to: path-fellowships@uabmc.edu
Address letters of recommendation to:
Cristina Magi-Galluzzi, M.D., Ph.D.
Chair, UAB Pathology
Section Head, GU pathology
Director, GU Pathology Fellowship Program
The C. Bruce Alexander Endowed Professorship in Pathology
The University of Alabama at Birmingham
619 19th Street South, HSB 149M, Birmingham, AL 35249
Genitourinary Pathology Fellowship Information
Stephanie Hobbs
Program Coordinator
Telephone: (205) 975-4230
Email: path-fellowships@uabmc.edu
Website: https://www.uab.edu/medicine/pathology/education/fellowship-program